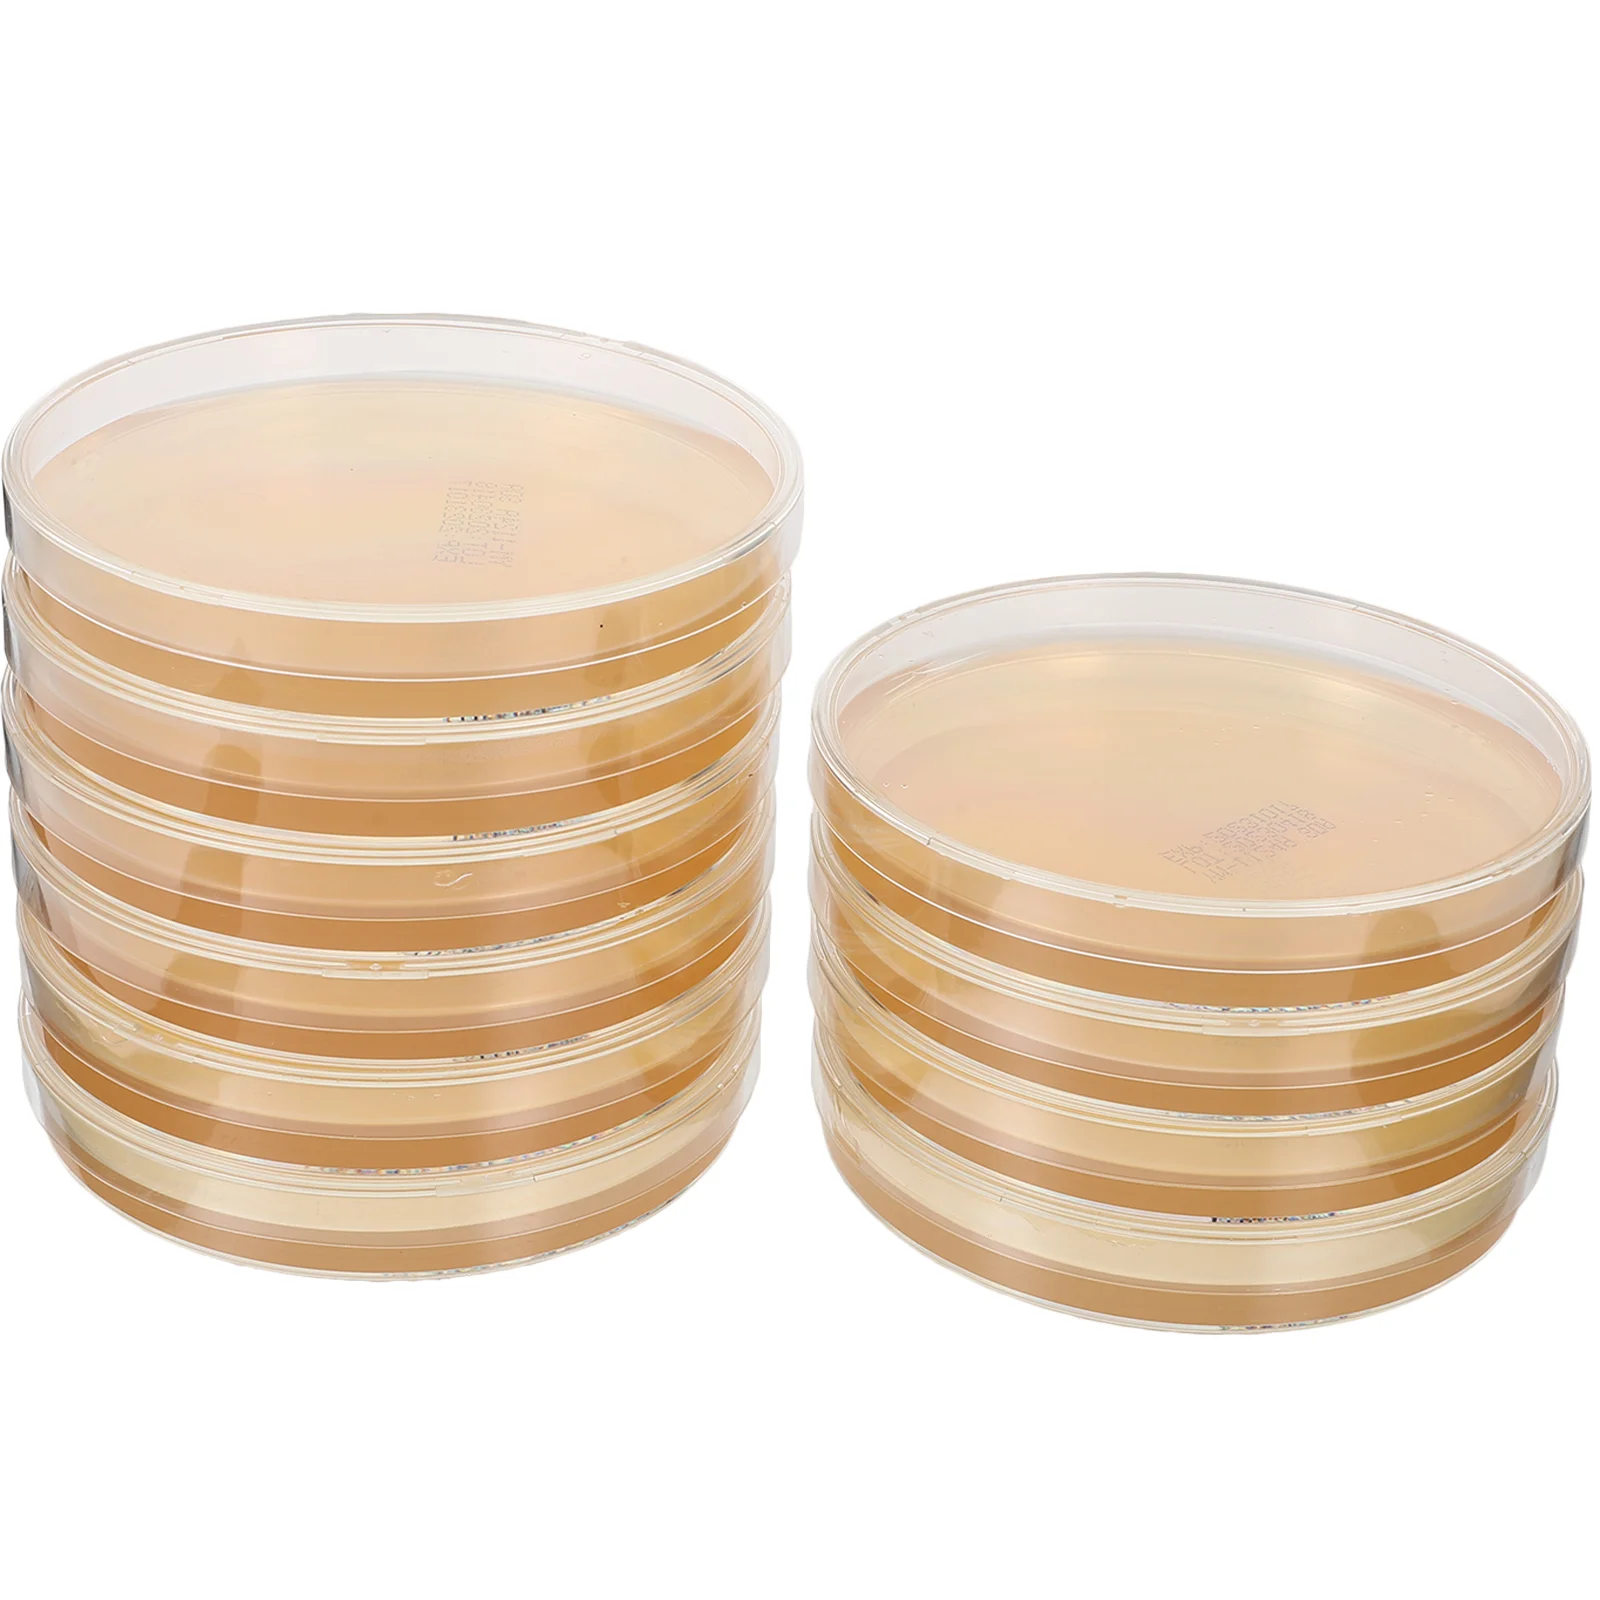
thumb

30 шт. питательные Агаровые тарелки научные эксперименты поставки тарелки для проектов лабораторные экспериментальные маленькие профессиональные Петри глюкозы
Price history chart & currency exchange rate
Customers also viewed

$2.39
Planting Bag Grey Potato Fabric Vegetable Seedling Pot Garden Tools 1-15 Gallon Eco-Friendly Grow
aliexpress.com
$25.67
Super Bright Outdoor IP66 Aluminum COB LED Waterproof Floodlight 30W 50W 100W 150W Porch Garden street Led spotlight Floodlights
aliexpress.com
$7.36
Эвакуационный молоток, Практичный Прочный инструмент из нержавеющей стали для эвакуации, противоскользящие портативные автозапчасти, многофункциональные
aliexpress.com
$41.73
NEW F1 Boring Set 2Inch 50/75/100mm F1 Type Boring Head 12/18/25mm Lathe Milling Holder Boring Bar Set
aliexpress.com
$1,669.22
IP68 IR 3 Million Pixels IP Explosion Proof Camera Gas Station Anti-explosion IP Poe Camera
aliexpress.com
$65.00
15,6-дюймовый ЖК-экран FHD, 144 Гц, 72% NTSC, 40 контактов, FHD IPS, панель дисплея для LP156WFG-SPB2 SPF2 NV156FHM-N4K LP156WFG-SPM1 5D10R19779
aliexpress.ru
$33.99
6,01 "Оригинальный Super AMOLED для Xiaomi Mi A3 ЖК-дисплей + сенсорный экран дигитайзер в сборе Замена ЖК-дисплея для Xiaomi CC9e LCD
aliexpress.ru
$45.57
STARPAD для Kawasaki 400 ZZR400, лобовое стекло мотоцикла, лобовое стекло, стекла, лобовое стекло
aliexpress.ru
$107.77
New Loose Hole Men Jeans Fashion Straight Casual Trousers High Quality Light Color Mens Denim Pants
aliexpress.com
$29.26
NEW 1.8m 2.1m 2.4m 2.7m Superhard carbon lure rod fast Casting Rods and Casting Reels Fishing Set beginner Rod Reel Combos
aliexpress.com
$2.10
Наклейка "Машины у ворот не ставить" Правильная Реклама 20х20 см, ламинированная, Желтый, Наклейка "Машины у ворот не ставить"
goods.ru
$22.04
Women's T shirt Tee Wine Red Purple Heart Quarter Zip Print Short Sleeve Valentine Weekend Basic Round Neck Regular Painting Couple S
miniinthebox.com
$39.68
Women's Swimwear One Piece Normal Swimsuit Mesh Patchwork Solid Color Black Bodysuit Bathing Suits Sports Summer
miniinthebox.com
$95.74
designer bags petite boite chapeau mm pm handbag purse original cowhide trim canvas hatbox shoulder bags leather luxury lady classic flowers
dhgate.com
$52.70
stylish slippers tigers fashion classics slides sandals men women shoes tiger cat design summer huaraches home, Black
dhgate.com
$74.49
2021 women printing sandals thick bottom slippers platform alphabet lady sandal patent leather designer fashion shoes240h, Black
dhgate.com
$53.07
usb hip hop ladies backpack fashion white women bags large capacity student bag casual travel backpacks292u
dhgate.com
$1.21
50pcs Plastic Plant Clips Supports Connects Reusable Protection Grafting Fixing Tool Gardening Supplies for Vegetable Tomato
aliexpress.com
$3.24
12 Colors/Set Nail Round Sequin Set Ultra Thin Flakes Sequins DIY Nail Decorations RP
aliexpress.com
$28.86
link, chain us7 bling bracelet iced out cubic zirconia for men single row 10mm geometric square tennis bracelets hip hop jewelry, Black
dhgate.com
$6.29
remote controlers voice control controller rc802v fmr1 for tcl tv 65p8s 49s6800fs 49s6510fs
dhgate.com
$14.00
Motorcycle For Ducati Superbike 1098 2007-2009 Ducati 1198 2009-2019 Motorcycle LCD Electronics 1-6 Level Gear Indicator Digital
aliexpress.com
$31.90
Man Tracksuit Oversize 3-16 Years Kids Hoodie Wolf Zipper Sweatshirt Women High Quality Creative Wolf Hooded Jackets Kids Top
aliexpress.com
$33.49
Push Up Bikini 2021 New Two Piece Swimsuit Women High Waist Black Pink Bikinis Set Swimwear Brazilian Beachwear Bathing Suit 2XL
aliexpress.com
$4.21
ej glaze for kids beads glass cabochon maxi multilayer black/brown leather bracelet bangle jewelry bejeweled butterfly, Golden;silver
dhgate.com
$18.57
sport 2020 summer new cotton t-shirt hip hop printed short sleeve men t shirt fashion brands men harajuku tee shirt streetwear
dhgate.com
$11.39
bask clothes summer female beach sunscreen cardigan solid color long sleeve cape women fashion loose coat prevent, Black
dhgate.com
$20.00
Motorcycle Accessories Radiators Grille Guard Cover Protector Protection Radiator Guards For Yamaha XSR900 GP 2024-2025-2026
aliexpress.com